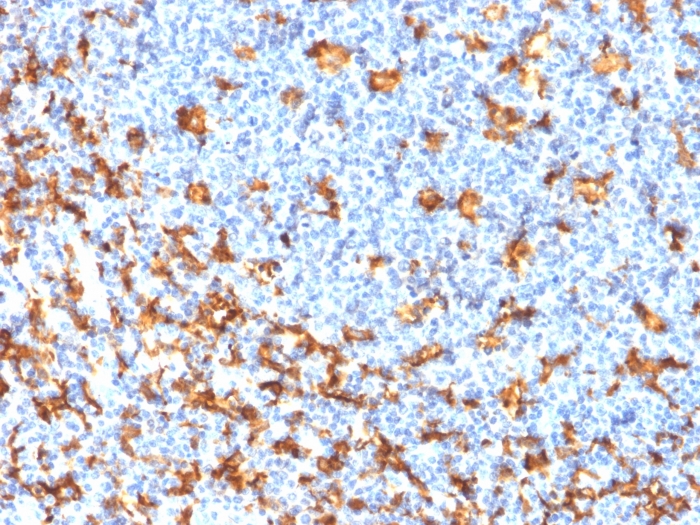

Formalin-fixed, paraffin-embedded Human Tonsil stained with AIF1 / Iba1 Mouse Recombinant Monoclonal Antibody (rAIF1/1909).

Analysis of Protein Array containing >19,000 full-length human proteins using AIF1 Mouse Monoclonal Antibody (rAIF/1909) Z- and S- Score: The Z-score represents the strength of a signal that a monoclonal antibody (MAb) (in combination with a fluorescently-tagged anti-IgG secondary antibody) produces when binding to a particular protein on the HuProtTM array. Z-scores are described in units of standard deviations (SD's) above the mean value of all signals generated on that array. If targets on HuProtTM are arranged in descending order of the Z-score, the S-score is the difference (also in units of SD's) between the Z-score. S-score therefore represents the relative target specificity of a MAb to its intended target. A MAb is considered to specific to its intended target, if the MAb has an S-score of at least 2.5. For example, if a MAb binds to protein X with a Z-score of 43 and to protein Y with a Z-score of 14, then the S-score for the binding of that MAb to protein X is equal to 29.
AIF1 is a cytoplasmic, calcium-binding protein that is thought to play a role in macrophage activation and function. AIF1, containing two EF domains, is induced by cytokines and Interferons. In an unstimulated state, AIF1 colocalizes with actin, and upon stimulation, translocates to lamellipodia. It is also a marker of human microglia and is expressed by macrophages in injured skeletal muscle. The gene encoding AIF1 resides in the tumor necrosis factor (TNF) cluster of genes, located in the region represented by the human major histocompatibility complex (MHC).
There are no reviews yet.